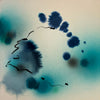
I Made This Up

I Made This Up
Celia Lees (b. 1996) is a contemporary abstract painter based in Toronto, Canada, known for expressive, gestural compositions that explore emotion, presence, and the act of painting in the moment. Working within the language of abstraction, Lees creates dynamic, large-scale works that balance instinctive mark-making with a refined sense of composition, resulting in paintings that feel both energetic and deeply considered.
Her practice is rooted in process and intuition, using layered applications of paint, sweeping gestures, and physical engagement with the canvas to capture what cannot be easily articulated. Embracing spontaneity and controlled chaos, Lees’ abstract paintings evoke a sense of immediacy and emotional depth, inviting viewers to experience rather than simply interpret the work. Each piece reflects an ongoing exploration of self-expression and connection.
Celia Lees’ paintings are held in private collections across Canada, the United States, Europe, and Asia, and have been selected for prominent residential and commercial interiors, including 200 Amsterdam in New York, Aria in Las Vegas, and The Laurel in West Palm Beach. Her work resonates strongly within architectural and design-led spaces, where her bold, atmospheric compositions add sophistication and visual impact.
Represented by Bau-Xi Gallery since 2025, Lees continues to gain recognition as a rising voice in contemporary Canadian abstraction.
Lees’ paintings are ready to hang unframed. Custom framing is available, contact a gallery associate to learn more.